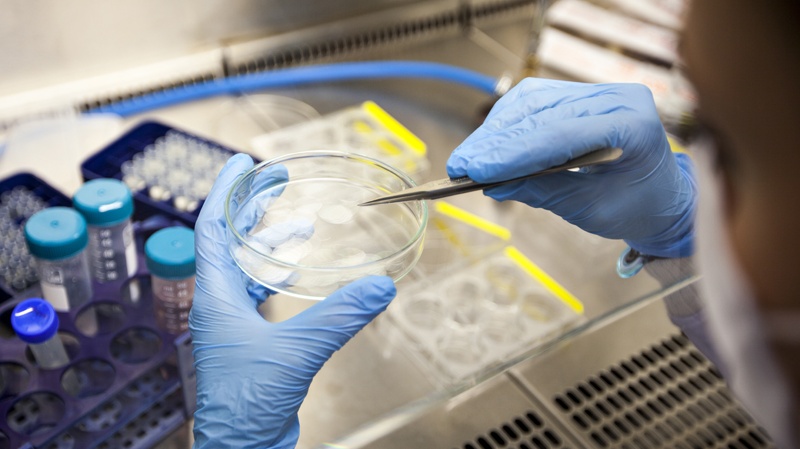
एचआईवी के इलाज के एक कदम और करीब पहुंचे शोधकर्ता

वैज्ञानिकों ने एचआईवी के इलाज की खोज में एक बड़ी सफलता हासिल की है। एक अध्ययन से ऐसी सफलता मिली है जिसे अभी तक ‘असंभव’ माना जाता था।
एचआईवी में खुद को श्वेत रक्त कोशिकाओं (WBC) में छिपा लेने की खूबी होती है। जिसका मतलब है कि न तो प्रतिरक्षा प्रणाली और न ही दवाएं इसे ढूंढ सकती हैं और न ही इसे नष्ट किया जा सकता है।
इसके बावजूद मेलबर्न में पीटर डोहर्टी इंस्टीट्यूट फॉर इंफेक्शन एंड इम्युनिटी के शोधकर्ताओं ने अब वायरस को उन कुछ मानव कोशिकाओं से निकालने का तरीका खोज लिया है, जिनमें यह छिपा होता है।
इस खोज से संभावित रूप से प्रतिरक्षा प्रणाली या दवाओं को वायरस की पहचान करने के साथ उसे समाप्त करने की अनुमति मिल सकती है, जिसका अर्थ है कि शोधकर्ता इलाज के एक कदम और करीब पहुंच गए हैं।
डोहर्टी इंस्टीट्यूट में एक रिसर्च फेलो और नेचर कम्युनिकेशंस में प्रकाशित अध्ययन की सह-लेखिका डॉ. पाउला सीवाल ने द गार्जियन को बताया कि कोशिकाओं तक आनुवंशिक संदेश या mRNA पहुंचाना पहले असंभव माना जाता था, क्योंकि कोशिकाएं संदेश ले जाने वाले लिपिड नैनोपार्टिकल्स (LNP) को स्वीकार नहीं करती थीं।
लेकिन फिर टीम ने एक नए प्रकार के लिपिड नैनोकणों का विकास किया, जिससे रक्त कोशिकाओं तक mRNA तकनीक पहुंचाना संभव हो गया। यह mRNA फिर कोशिकाओं को अपने संदेश में वायरस को व्यक्त करने के लिए कहता है।
डॉ. पाउला ने समाचार पत्र से कहा कि टीम को शुरू में लगा कि परिणाम बहुत अच्छे थे, लेकिन उन्हें उम्मीद थी कि नया नैनोकण डिजाइन एचआईवी के इलाज का एक नया तरीका हो सकता है।
उन्होंने कहा- “हमने प्रयोग को दोहराने के लिए उसे प्रयोगशाला में वापस भेजा और अगले सप्ताह हमें उतने ही अच्छे परिणाम मिले। इसलिए हमें इस पर विश्वास करना पड़ा और निश्चित रूप से हमने उसके बाद इसे कई बार दोहराया।
आगे वह कहती हैं- “हम सभी इस बात से हैरान थे कि इसने कितना बड़ा अंतर किया। यह पहले काम नहीं कर रहा था और फिर अचानक यह काम करने लगा और हम सभी हैरान रह गए।”
उन्होंने आगे कहा- “बायोमेडिसिन में बहुत सी चीजें क्लिनिक तक नहीं पहुंच पाती हैं और यह एक दुखद वास्तविकता है, मैं इससे बेहतर तस्वीर नहीं दिखाना चाहती। लेकिन अगर हम विशेष रूप से एचआईवी उपचार के क्षेत्र की बात करें, तो हमने वायरस का पता लगाने के मामले में इससे बेहतर कुछ कभी नहीं देखा है। इस तरह से, हमें उम्मीद है कि हम जानवरों में भी इसी तरह की प्रतिक्रिया देख पाएंगे और अंततः मनुष्यों में भी इस पद्धति को आजमा पाएंगे।”
यह अध्ययन एचआईवी से संक्रमित रोगियों की कोशिकाओं पर किया गया था। अब यह देखने के लिए और अधिक शोध की आवश्यकता है कि क्या प्रतिरक्षा प्रणाली वास्तव में वायरस को उजागर करने के बाद उसे खत्म कर सकती है। इस नई खोज को मानव परीक्षणों में इस्तेमाल किए जाने से पहले कई वर्षों तक और सुरक्षा परीक्षण की आवश्यकता होगी।
